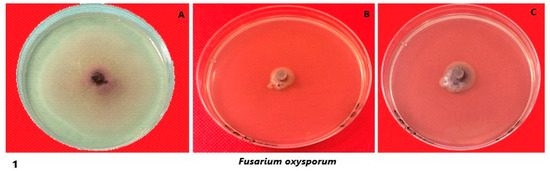
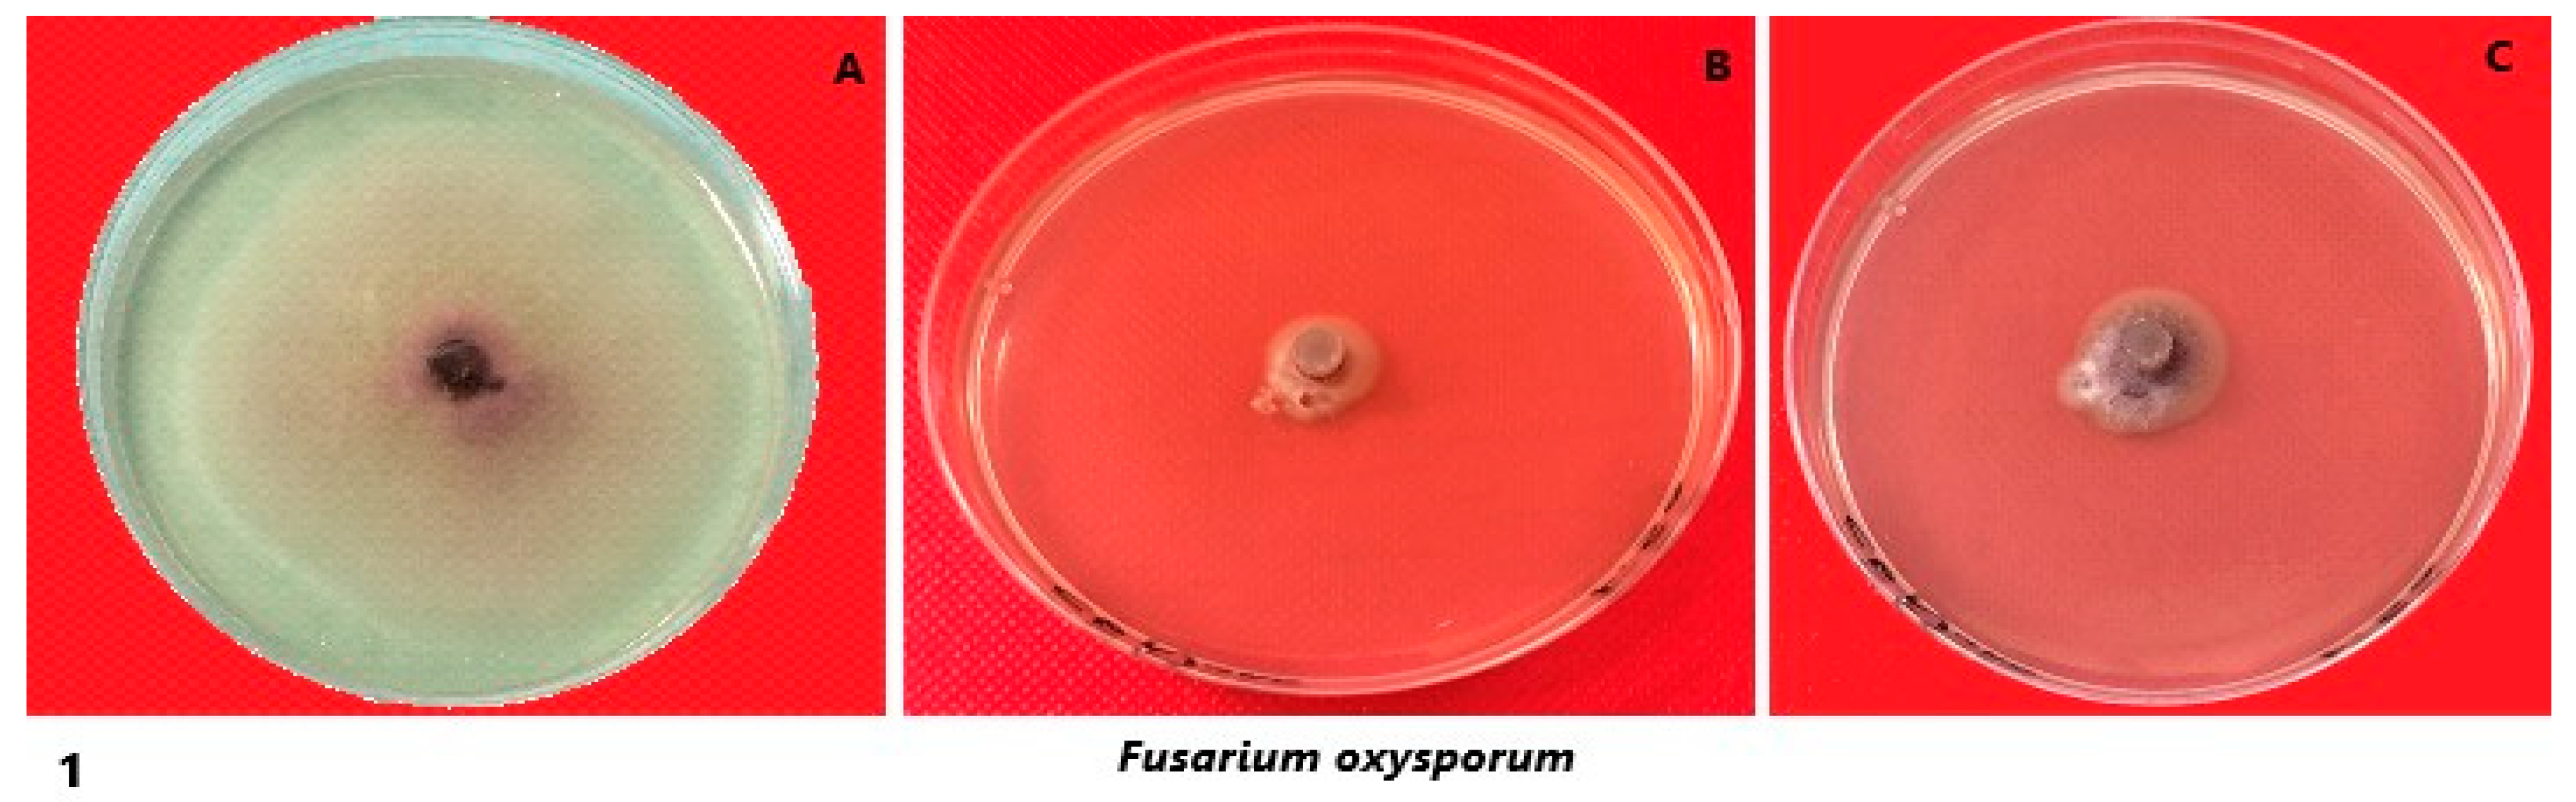
Crystals 13 00294 g005a
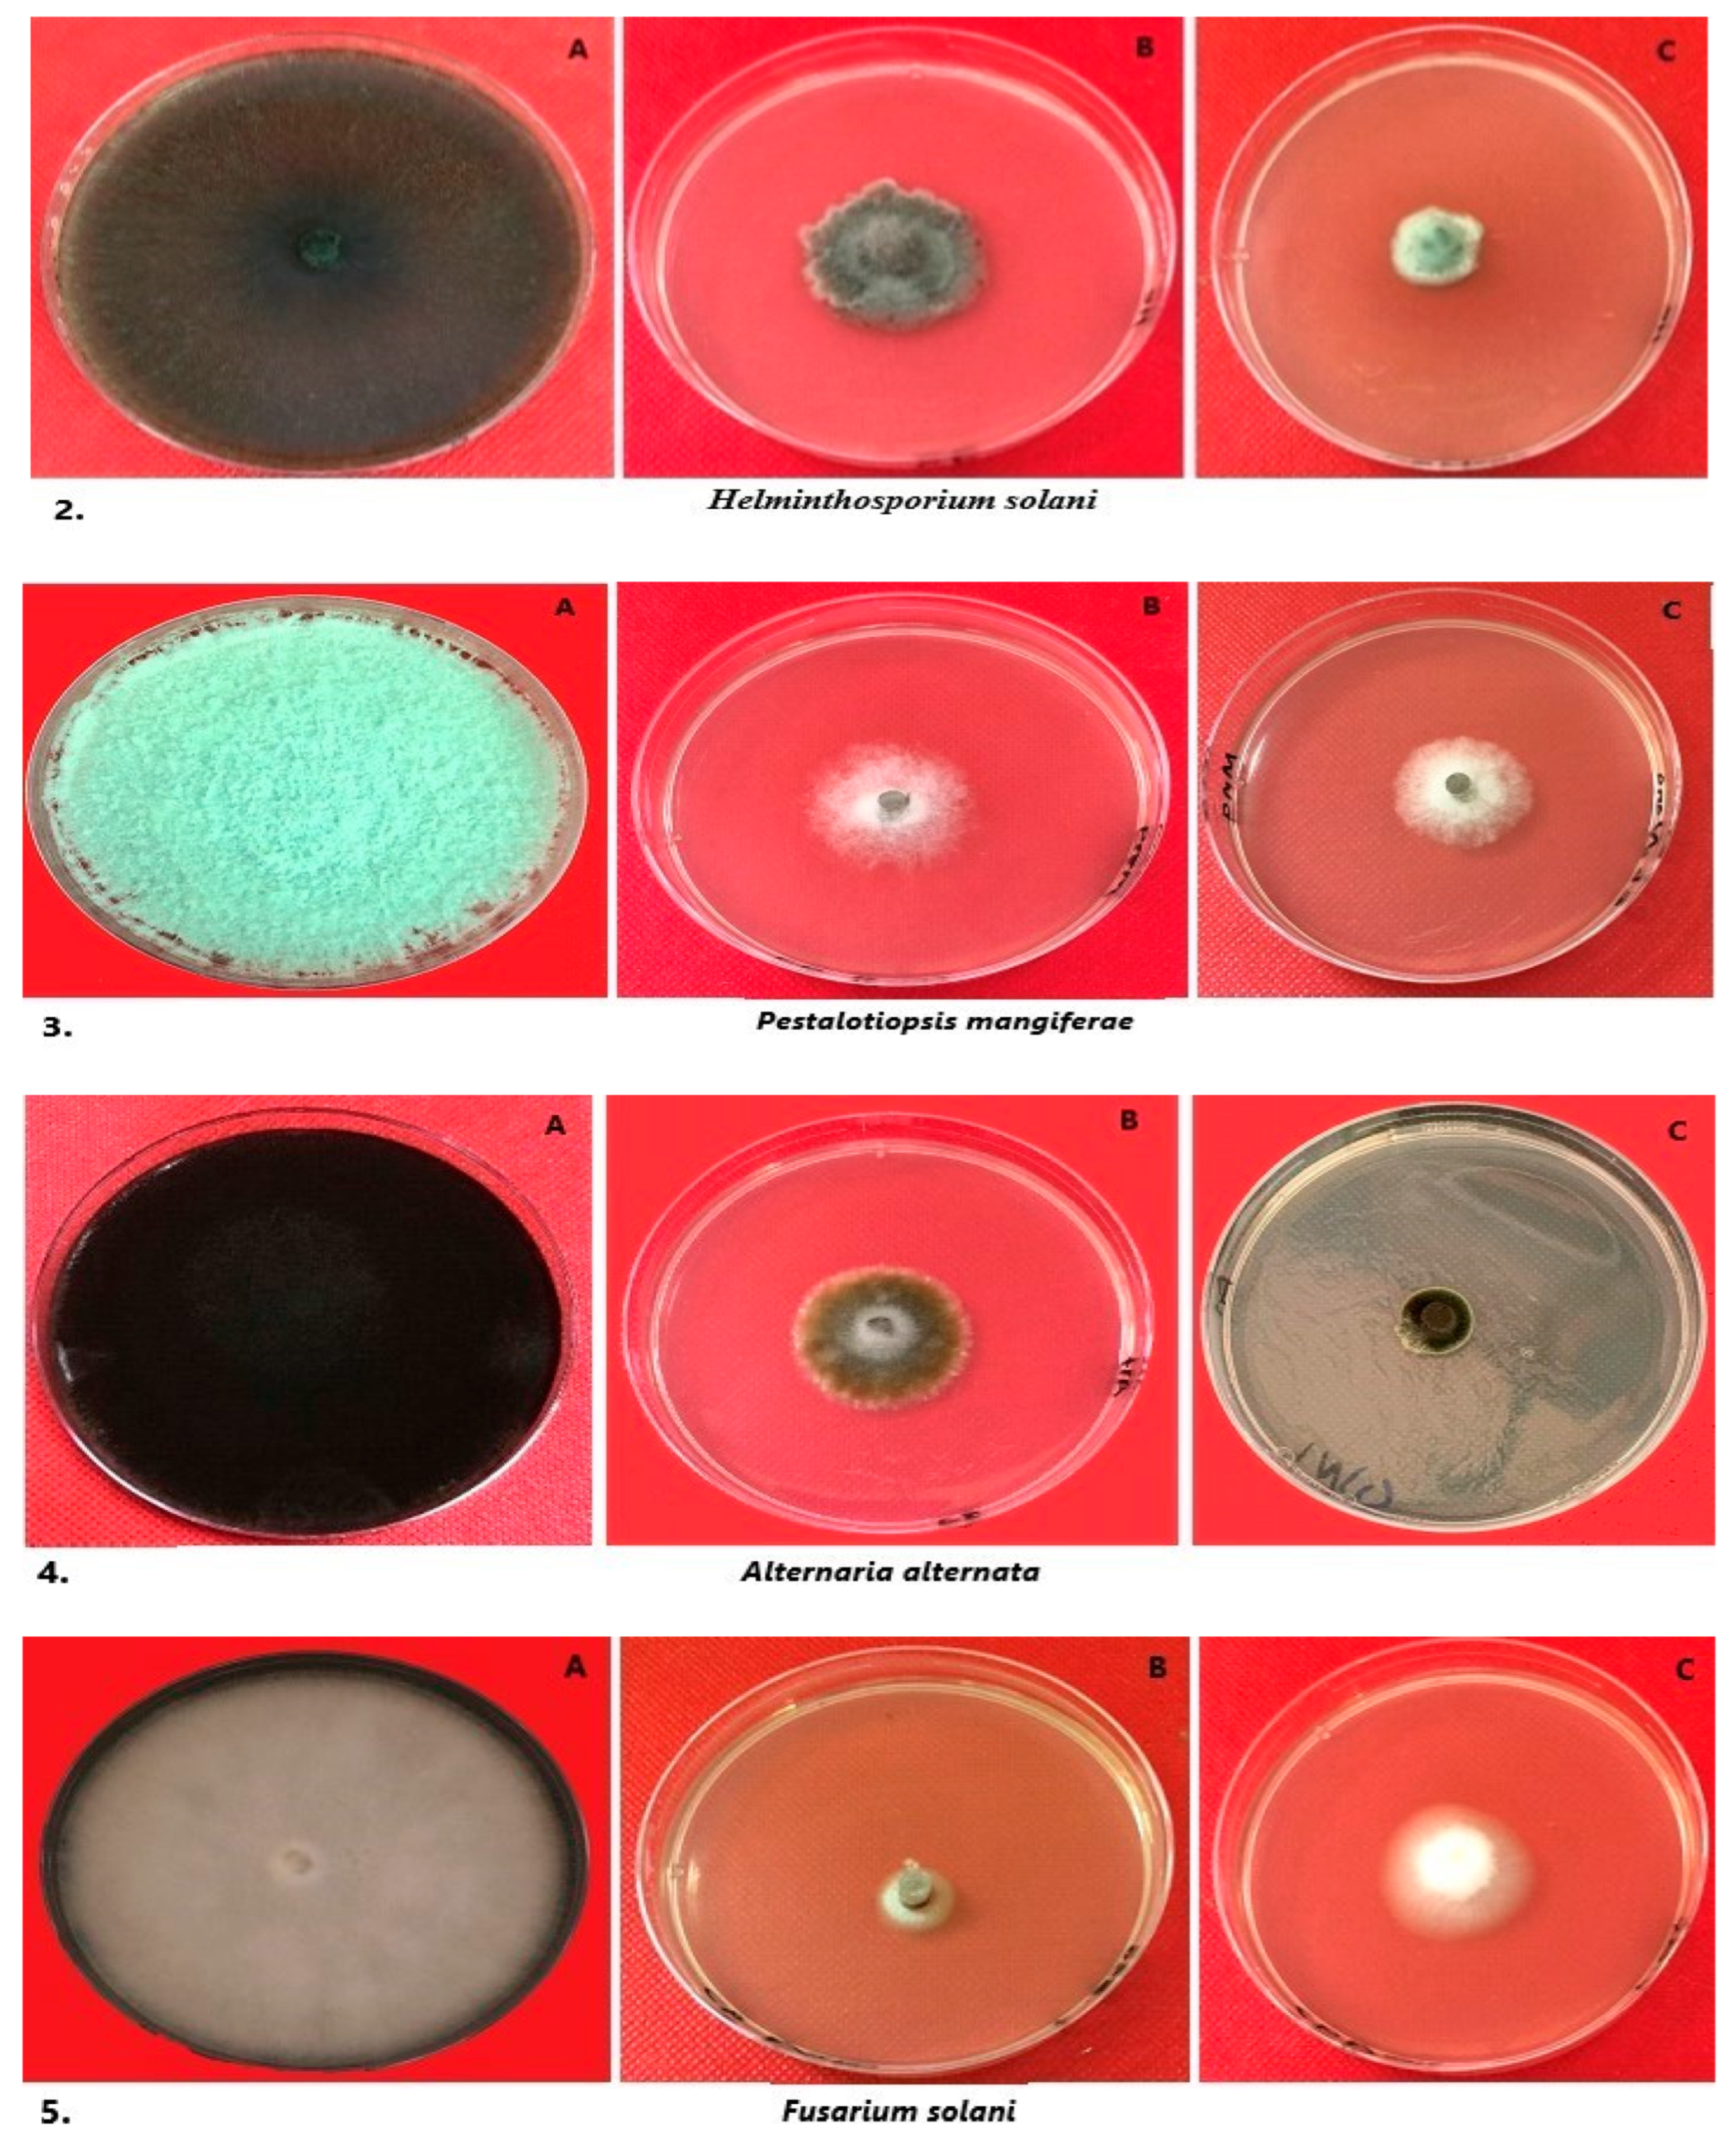
Crystals 13 00294 g005b
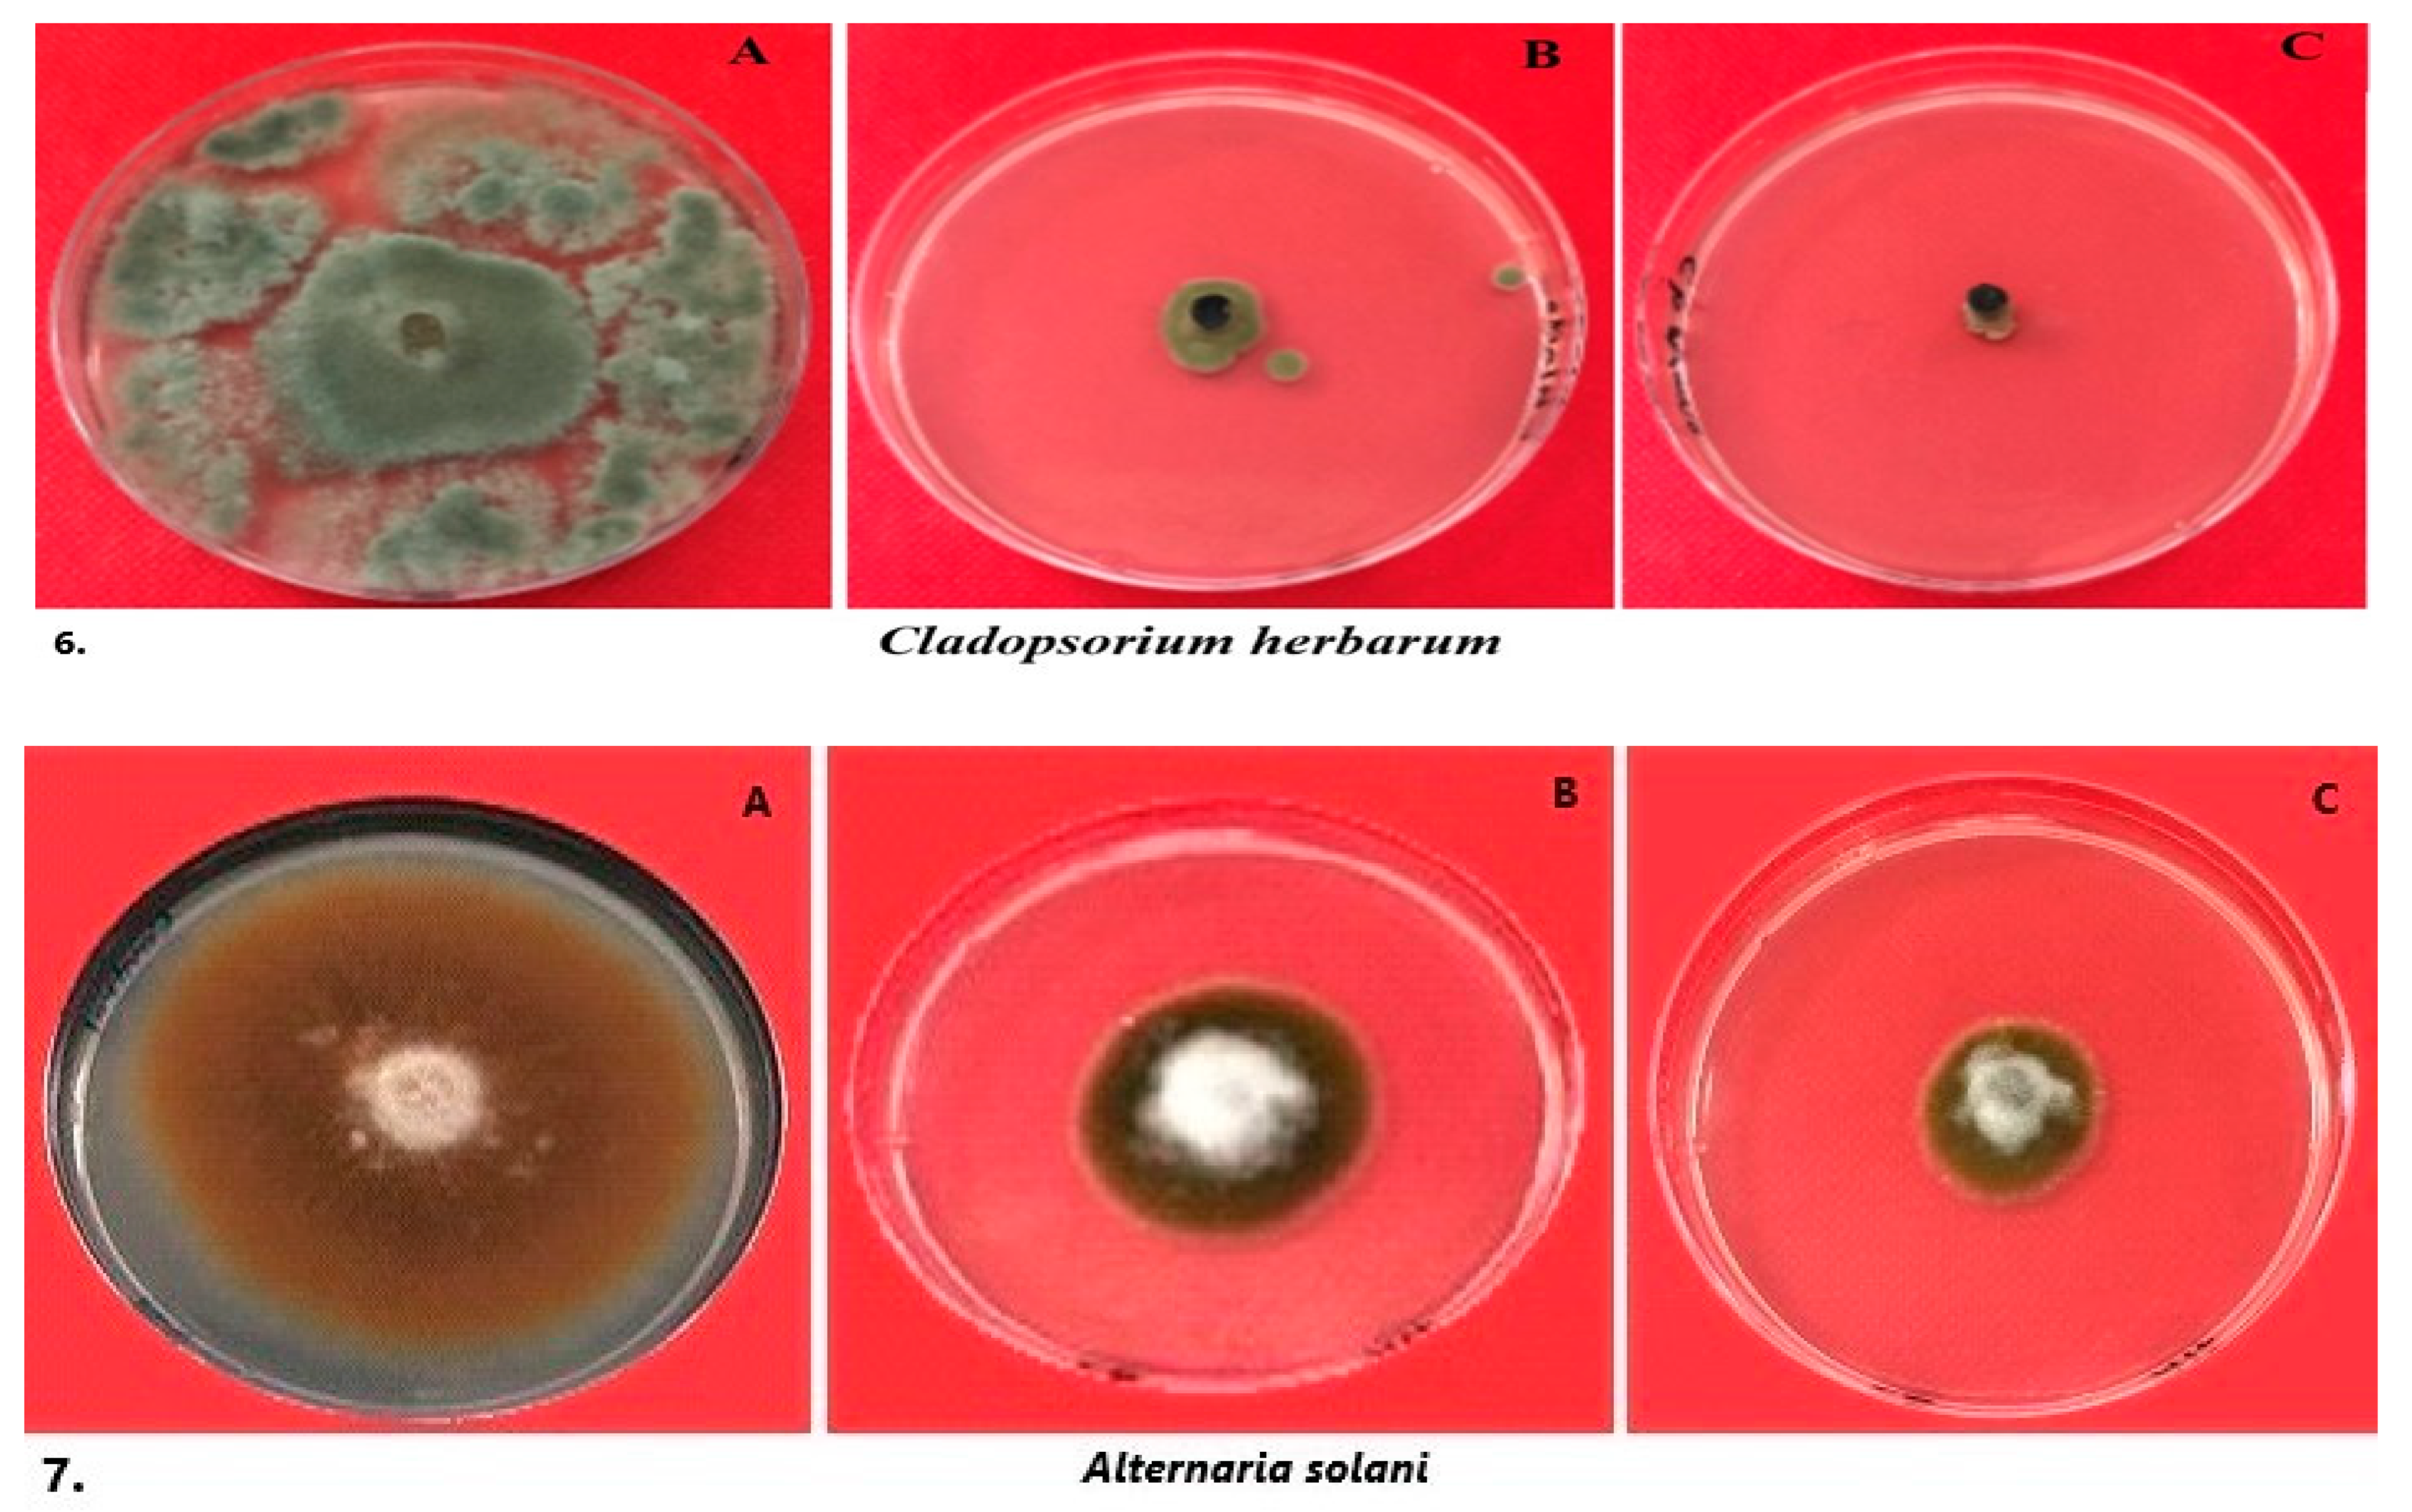
Crystals 13 00294 g005c

Abstract
Eco-friendly preparation of metallic nanoparticles (NPs) is a greatly evolving field of scientific research. These types of NPs have gained substantial recognition from scientists, including chemists, chemical biologists and technologists, who have successfully exploited them for the fabrication of a variety of advanced nanodevices. Herein, silver (Ag) NPs were synthesized by a green approach using the aqueous extract of Vaccinium oxycoccos (cranberry), which not only reduced the silver ions but also stabilized the surface of the resultant Ag NPs. The formation of Ag NPs is confirmed by different analytical techniques, including powder X-ray diffraction, UV analysis, scanning electron microscopy (SEM), energy-dispersive X-ray (EDX), transmission electron microscopy (TEM) and Fourier-transform infrared spectroscopy (FT-IR). The UV analysis of the aqueous solution of the reaction mixture demonstrated an absorption band at ~450 nm, which is the typical peak of Ag NPs, leading to the confirmation of product formation. While the XRD confirmed the crystallinity of the sample and the formation of a face-centered cubic (fcc) structure, on the other hand, TEM revealed the presence of spherical NPs with an approximate size range between 5–30 nm. Furthermore, the as-obtained Ag NPs were subjected to thorough investigations to explore the biomedical potential of the sample. In this case, the Ag NPs demonstrated considerable antioxidant and antifungal properties towards various pathogens. In addition, Ag NPs also showed substantial inhibition of spore germination.
1. Introduction
Over the years, metallic materials at the nanoscale level (metallic nanoparticles) have fascinated researchers and are currently being applied in a variety of applications in various fields, such as engineering, agriculture, medicine, etc. [1,2]. The extensive utilization of these materials is attributable to their unique physicochemical properties, such as excellent catalytic, electric, electronic, and physical properties [3,4]. Of all the available metallic NPs, silver (Ag) NPs have received remarkable recognition due to their distinctive plasmonic properties, as well as their wide-ranging potential biological applications. Metallic Ag has been used historically in various fields for materials and medicines and in applications such as the treatment of diseases like pleurodesis, cauterization, and healing skin wounds [5]. In addition, Ag NPs have been extensively applied as antibacterial agents in biomedical industries, as textile coatings, for food storage and in several environmental applications [6]. Indeed, Ag has been successfully applied for the prevention of a variety of microbial infections and for treating infections caused by several organisms [7]. In particular, the surface chemistry of Ag NPs plays an important role during the interactions with biological constituents, and thus, considerable efforts have been made to modify the surface of Ag NPs via functionalization with a variety of ligands [8]. The other biomedical applications of Ag NPs include cancer treatment, which has proven to be effective and captured the attention of medical researchers to develop various types of Ag NP–based therapeutic agents [9]. So far, a variety of Ag NP–based conjugates with chemotherapeutic anticancer drugs like doxorubicin, fluorouracil, peptides and folic acid, etc., have been developed as anticancer agents and for other cancer-related applications [10,11]. Clearly, Ag NPs and their conjugates possess great potential for applications in different fields of science and technology, particularly in biomedical and therapeutic applications [12]. Due to these broad varieties of applications, special attention has been given to the preparation of Ag NPs and their composites using different synthetic methods and diverse physical, chemical and biological techniques [13]. Generally, high-energy consumption, complex industrial instruments, high cost of production, etc., are limitations in the case of physical approaches, whereas the utilization of hazardous and volatile chemical reagents such as sodium borohydride, hydrazine hydrate, etc., inhibit the large-scale applications of chemical methods [14]. The shortcomings of these methods prompted the development of inexpensive, safe and green methods. Therefore, the green protocols for synthetic purposes are gaining significant acceptance from the scientific community.
In this scenario, the biological syntheses of nanoparticles, particularly Ag, has received great interest due to their environmental benignity, low cost, and relative ease of preparation [15]. These processes involve various media, such as extracts of cellular microorganisms like fungi, algae, bacteria and plants, which are applied as eco-friendly reducing as well as stabilizing agents [16]. In particular, aqueous solutions of these natural extracts are highly effective and have become more popular due to their non-toxicity and non-volatile nature [17]. Typically, biological extracts consist of a mixture of various types of active bio-constituents, such as vitamins, biopolymers, proteins and natural surfactants, which facilitate the synthesis of NPs and provide high stability and enhanced dispersibility to the resultant NPs [18]. In this regard, we prepared Ag NPs from the aqueous extract of Vaccinium oxycoccos (cranberry) and explored their antioxidant and antifungal properties against various microorganisms.
Different varieties of berries belonging to various families are typically considered as effective nutraceuticals because they consist of a wide range of bioactive compounds [19]. They often possess excellent biological properties, including antioxidant, anti-inflammatory and anti-cancer potential, and thus have received great attention from food technologists, nutritionists and medical professionals [20]. Among the different types of berries, Vaccinium oxycoccos (cranberry) belongs to a popular variety of the genus Vaccinium of the family Ericaceae, which comprises more than 450 species across different continents, including North America, Central America, and Europe. Vaccinium oxycoccos, commonly referred to as “European cranberry” or “small cranberry” is known to contain high concentrations of a variety of biologically active phytoconstituents [21]. In particular, these plants are considered as rich sources of phenolic compounds and triterpenes, including flavonols, phenolic acids and anthocyanins. [22]. These active phytoconstituents display strong antioxidant potential and the ability to alleviate different chronic diseases [23]. Indeed, small cranberries have proven to be effective in the prevention of free radical reactions and the inhibition of oxidative processes, including oxidation of low-density lipoproteins as well as oxidative and inflammatory damage to the vascular endothelium [24]. They are also used for various specialized treatments, such as fpr urinary tract infections, the prevention of the accumulation of bacteria in the urinary tract, and the reduction of the formation of the mutagens streptococci [25].
Therefore, due to the rich content of bioactive phytoconstituents in cranberries and their high biological potential as explored in previously published studies, herein, we demonstrate the preparation of Ag NPs using the aqueous extract of small cranberries. In addition, we also investigate the antioxidant and antifungal properties of as-prepared Ag NPs against various pathogens (Scheme 1).

Scheme 1.
Schematic representation of as-synthesized silver nanoparticles using cranberry extract and evaluation of their biomedical potential.
2. Materials and Methods
2.1. Chemicals Reagents and Culture Media
In the present study, the chemicals and reagents used were pure (99% purity) and of standard analytic grade. Silver nitrate, potato dextrose agar (PDA), DPPH (2,2-diphenyl-1-picrylhydrazyl), fungicide, ultra-pure water, and distilled water were procured either from Hi Media Labs (Mumbai, India) or Sigma-Aldrich (Saint Louis, MO, USA).
2.2. Preparation of Aqueous Berry Extract
Fresh cranberries were purchased from a local market in Riyadh, Saudi Arabia. Disease-free berries were washed, the seeds were removed, and they were finely chopped. The aqueous extract was prepared by adding the chopped cranberries to 100 mL of distilled water, heated for 20 min at 60 °C. The berry mixture was cooled and then filtered (Whatman’s filter paper, No. 1). The filtrate was centrifuged (5000 rpm) and used for further experimental work in this study.
2.3. Fungal Pathogens
An array of fungal isolates was used in the present study. The fungal pathogens Fusarium solani, Fusarium oxysporum, Cladosporium herbarum, Alternaria solani, Alternaria alternata, Helminthosporium solani and Pestalotiopsis mangiferae were procured from the Department of Botany and Microbiology, College of Science, King Saud University, Riyadh, Saudi Arabia.
2.4. Synthesis of Silver Ag NPs from Cranberry Extract and UV-Vis Spectroscopy
A total of 5 mL cranberry extract was added to 45 mL of freshly prepared 1 mM silver nitrate solution, and the suspension was allowed to turn red in color. Further, the suspension was incubated at 80 °C and closely monitored for any change in color. The successful biosynthesis of silver NPs from cranberry was visually noticed when the reaction suspension changed color (Figure 1). To ensure the biosynthesis of NPs, the reaction mixture was subjected to UV-Vis spectroscopic analysis with an ultraviolet-visible spectrophotometer (Shimadzu, Japan—model No. 1800). After this, the sample was isolated by centrifugation at 9000 rpm; this resulted in the formation of dark brown powder, which was washed several times with DI water to remove excess of cranberry extract. The powder was kept in an oven at 50 °C for several hours and later used for further characterizations and other studies.

Figure 1.
Image of aqueous solution of AgNO3, V. oxycoccos (cranberries) aqueous extract, and suspension after 24 h of stirring at room temperature.
2.5. Characterization of the Biosynthesized Cranberry Ag NPs
The synthesized NPs were characterized, and their size and shape were determined with a transmission electron microscope (TEM-JEOL JEM-Plus-1400, Tokyo, Japan) and Zetasizer (model: Nano Series—ZEN-3600, Malvern, UK). The elemental composition of synthesized NPs was determined with a field emission scanning electron microscope coupled with an energy dispersive X-ray detector (FESEM-EDAX-JSM-7610F-Japan) at 30 kV. The IR spectrum was captured using a Fourier transform infrared spectroscope (FT-IR Model-Nicolet-6700, Thermo Scientific, Waltham, Massachusetts, USA,). The cranberry extract and biosynthesized Ag NPs were scanned in the range of 400–4000 cm−1. After the completion of the reduction of Ag+, the resulting reaction mixture was centrifuged at 15,000 rpm for 30 min to remove the Ag-NPs from the aqueous solution of proteins and other compounds. This process was repeated several times (3 times), with the addition of more DI water to thoroughly separate the NPs from the non-binding residual phytomolecules. All the aforementioned characterization techniques were conducted in accordance with the manufacturer’s instructions.
2.6. Determination of the Inhibitory Effect of Cranberry Ag NPs and Extract on Fungal Pathogens
The effect of cranberry extract and cranberry NPs on the colony growth of Fusarium solani, Fusarium oxysporum, Cladosporium herbarum, Alternaria solani, Alternaria alternata, Helminthosporium solani and Pestalotiopsis mangiferae was determined with an antifungal assay as described by Rizwana et al., 2021 [26], and Kim et al., 2012 [27]. The pure fungal cultures of all the test isolates were subcultured separately on potato dextrose agar (PDA) for 7 days and used for the antifungal assay. Various concentrations (2, 4, 8, 16, 32 and 64 µg/mL) of cranberry extract, cranberry NPs, fungicides (carbendazim and mancozeb, 0.1% C and M), and AgNO3 (0.1 mM) were added to sterilized PDA media separately. The amended media was then used to evaluate the inhibitory potential of all the aforementioned tested solutions against the fungal isolates used in this study. Briefly, PDA media amended with different concentrations of test suspensions were transferred to sterilized Petri dishes, and the media was left at 25 °C. After the media solidified, a small mycelial disc measuring 6 mm was placed in the center of the amended PDA plate in an upside-down manner. The disc was removed aseptically from the outer surface of 7-day-old pure fungal culture plates. Positive and negative controls were PDA amended with the fungicides carbendazim and mancozeb (0.1% C + M) and plates containing only PDA media and fungal mycelial discs. The PDA plates, treated with different suspensions or solutions, and the control plates were incubated at 28 °C for 7 days. All the fungal isolates were tested in a similar manner, as specified above. Each experiment was conducted three times. The results were noted after 7 days by measuring the colony growth, and the inhibition percentage was calculated.
2.7. Inhibitory Effect of Cranberry Ag NPs on the Spore Germination of Fungal Pathogens
Different concentrations of cranberry Ag NPs (2, 4, 8, 16, 32 and 64 µg/mL−1) were tested for their inhibitory effect on the spore germination [28]. To make the final concentrations, test tubes were filled with equal volumes (500 µL) of cranberry NPs and spore suspension, with a spore density of 1 × 106 spores/mL−1. Spore suspension was prepared with potato dextrose broth by following the method of Rizwana et al. [29], with a few modifications. The same procedure was followed with cranberry extracts. The test tubes with spore suspension and distilled water served as a negative control, while the spore suspension with fungicide served as a positive control. All the treated test tubes were incubated at 28 °C, and the results were recorded after 24 h. The number of spores that germinated were counted on a hemocytometer. The percentage of spores inhibited was recorded for 100 spores for each treatment and for controls [29,30]. The experiment was repeated three times for each concentration against each test isolate.
2.8. Evaluation of Antioxidant Activity with the DPPH Scavenging Assay
The free radical scavenging activity of the biosynthesized Cb-AgNPs was estimated with the 2,2-diphenyl-1-picrylhydrazyl (DPPH) radical scavenging assay with a slight modification [31]. Precisely, 0.1 mM DPPH solution was prepared in methanol. Various concentrations (25, 50, 100, 150 and 200 μg/mL−1) of Ag NPs were added to the DPPH solution to obtain the final concentrations. The mixture solutions were thoroughly agitated and incubated in the dark at 37 °C for 30 min. After 30 min, the absorbance of solutions was measured at 517 nm. Similar to Ag NPs, the assay was conducted with various concentrations of standard ascorbic acid solutions (control), and absorbance was recorded at 517 nm. DPPH solution without the sample served as a blank. The DPPH scavenging activity was calculated with the formula given below and expressed as %, while the IC50 value of the standard (ascorbic acid) and Ag NPs was calculated by linear regression analysis [32,33] by plotting a dose-response curve between % inhibition and test concentrations. The assay was repeated three times, and the values are the means of three independent experiments.
where AC and ATs are the absorbance of the control (without extract) and ATs is the absorbance of the test sample.
DPPH scavenging activity (%) = AC-ATs/AC × 100
2.9. Statistical Analysis
The data in the tables and figures in this study represent values from triplicate experiments (SD). To detect significant differences, Tukey’s HSD tests (p = 0.05) and analysis of variance (ANOVA) (p = 0.05) were conducted using GraphPad Prism version 8.4.3.686 and XLSTAT (software version 2020).
3. Results
The reduction of Ag+ into Ag-NPs was visible by the change in the color of the solution upon the addition of the aqueous extract of the cranberries to the AgNO3 solution. The fresh aqueous solution of Vaccinium oxycoccos (V. oxycoccos) was red in color, while the AgNO3 solution was colorless; however, upon mixing these two solutions and stirring for 30 min at 80 °C, the suspension turned brown in color. The change in color of the suspension occurred due to the surface-plasmon resonance (SPR) phenomenon. The preparation of Ag NPs was further confirmed spectroscopically by recording the UV spectra of the aqueous solution of cranberry extract (green line) and Ag NPs (red line) suspension over the wavelength range of 300–950 nm, as shown in Figure 2. The UV spectrum of cranberry extract exhibits a visible peak in the measured spectral region (green line in Figure 2a). Typically, polyphenols, which are abundantly present in the cranberry extract, are sensitive to UV/Vis absorption due to the electronic transitions between π-type molecular orbitals (MOs), which broadly extend over their molecular backbone [34]. Most of the polyphenolic constituents usually exhibit at least two absorption peaks in their UV/Vis spectra, one (Band I) ranging from 240 to 280 nm and another (Band II) from 300 to 400 nm [35]. As shown in Figure 2a, green line, there is a sharp absorption peak at ~280 nm and a very small and broad peak at ~382 nm, which indicates the presence of polyphenolic constituents in the cranberry extract. On the other hand, the UV spectrum of Ag NPs demonstrates a sharp shoulder peak at ~278 nm and another slightly broad but prominent peak at ~451 nm (red line in Figure 2a). Previously published studies have suggested that the SPR peaks are typically affected by the shape, size, morphology and composition of the resultant material [33]. Typically, well-defined, spherical Ag nanoparticles lead to the sharp absorption peak between 400–450 nm in the UV-visible spectra. Thus, the appearance of a slightly broad peak in the region of ~451 nm in the case of Ag NPs prepared from cranberry extract points towards the formation of nanoparticles. Whereas the sharp shoulder peak at 278 represents the residual polyphenolic constituents that remained attached to the surface of resulting Ag NPs as a stabilizing agent. Furthermore, to confirm the presence of residual organic moieties on the surface of Ag NPs, the sample is subjected to thermogravimetric analysis (TGA) [36]. Figure 2b displays the TGA of the stabilized Ag NPs with residual organic phytoconstituents when heated from 20 to 950 °C. The initial ~5 to 6% weight loss observed up to ~250 °C represents the degradation of water molecules present in the stabilized Ag NPs. Whereas a sharp weight loss of around 35% in the temperature range of ~250 to ~500 °C is observed, which is most likely a consequence of the surface desorption of the bioorganic phytoconstituents present in the Ag NPs. Finally, from ~500 to ~900 °C, there is no major weight loss observed, which may account for the weight of the Ag NPs (up to ~60% Ag NPs). The XRD pattern of vacuum-dried as-prepared Ag NPs synthesized using cranberry extract is provided in Figure 2c. The XRD diffractogram of Ag NPs specified a face-centered cubic structure of Ag NPs. Notably, XRD peaks appeared at 2θ positions of 37.50° (111), 44.13° (200), 63.91° (220), 76.89° (311) and 81.13° (222), which are the characteristic crystallographic planes of the face-centered cubic silver crystals [37]. Thus, the XRD diffractogram clearly revealed that the Ag NPs obtained in the present study are of a crystalline nature. Moreover, only the Ag crystalline phase is visible, and no obvious other phases exist as impurities in the XRD diffractogram.

Figure 2.
UV-Vis spectrum and XRD diffractogram of Ag NPs prepared from the extract of cranberries. (a) UV spectra of pure cranberry extract (green line) and as-prepared Ag NPs (red line), (b) TGA analysis of Ag NPs and (c) XRD diffractogram of Ag NPs. Note: the peaks marked with asterisks could be due to the inorganic contents of the cranberry extract.
In order to ascertain the morphology of the resultant NPs, the sample was subjected to TEM analysis. For this purpose, a drop of the Ag NP dispersion prepared by treating AgNO3 solution with cranberry extract was placed onto a TEM copper grid, which was dried under vacuum and used for recording the image. The TEM image is displayed in Figure 3a; the results revealed the formation of well-defined, superbly distributed, smaller-sized, spherical-shaped Ag NPs with diameters in the range of ~5 to 25 nm. As shown in Figure 3a, the Ag NPs are enclosed by light-colored spots, which possibly appeared due to the presence of the organic phytomolecules of the cranberry extract as stabilizing ligands, which was previously indicated by UV and TGA analyses. This is further confirmed by FT-IR spectroscopy, as shown below. This result was further confirmed by DLS; the DLS pattern shown in Figure 3b demonstrates that the Ag NPs prepared from the extract of cranberries exhibit a Zeta average diameter of ~62.80 nm, with a polydispersity index (PDI) of 0.203. Notably, in this case, the measured DLS size is considerably larger when compared to the particle size measured from TEM analysis; this can be due to the difference in measurement techniques, as the DLS method measures the hydrodynamic radius [38]. Nevertheless, the DLS clearly confirms the high stabilization of the resultant Ag NPs by the active phytomolecules of the cranberry extract. Furthermore, the resultant sample was subjected to EDX analysis to confirm the existence of elemental Ag in the sample, as shown in Figure 3c. The spectrum clearly reveals the presence of elemental silver in the sample.

Figure 3.
(a) TEM, (b) DLS measurements image of Ag NPs prepared from the extract of cranberries and (c) elemental analysis of Ag NPs prepared from cranberry extract whole EDX spectrum.
Moreover, to ascertain the dual action of active secondary metabolites of the cranberry extract, i.e., as both reducing and stabilizing agents, during the preparation of Ag NPs, FT-IR analysis was performed. For that reason, the IR spectra of both the resulting Ag NPs and pure cranberry extract were recorded, and the spectra were compared. The FT-IR spectrum of pure cranberry extract (see Figure 4) helped in the identification of the possible biomolecules that facilitated the reduction of the Ag+ ions, while the IR spectrum of Ag NPs revealed the presence of phytomolecules on the surface of the resulting nanoparticles as stabilizing ligands to the bio-reduced Ag-NPs prepared by the cranberry extract.

Figure 4.
FT-IR pattern of pure cranberry extract powder and Ag NPs prepared using cranberry extract as reducing agent.
The FT-IR spectrum of pure cranberry extract (see Figure 4) demonstrated typical absorption peaks, which indicates the presence of rich polyphenolic contents [39]. For example, a broad peak around 3372 cm−1 corresponds to symmetric (sym) and asymmetric (asym) stretching of the polymeric hydroxyl group (O–H), H-bonded stretching, which is typical for polyphenolic phytoconstituents [40]. The peak at ~2933 cm−1 belongs to the stretching vibrations of -CH, -CH2 and -CH3, derived from carbohydrates and sugars in cranberry extracts. On the other hand, the peak at ~1728 cm−1 possibly appeared due to the oscillation of the carbonyl group (C=O) of aldehydes and sugar derivatives. In addition, the stretching of C=C–C and C–H belonging to the aromatic bonds exist at ~1640 cm−1. These oscillations demonstrated the presence of several aromatic rings in the structure of polyphenolic compounds. The peak observed at ~1250 cm−1 corresponds to the phenolic C–O stretching, which belongs to the pyran, typical of flavonoid C-rings. The appearance of all these peaks strongly suggests the presence of aromatic compounds. In particular, the fingerprint region between 1400 and 900 cm−1, consisting of several characteristic low-intensity single bands, can be ascribed to specific functional groups, such as, C-H, C-O, C-N and P-O bonds. In the case of the IR spectrum of Ag NPs (see Figure 4), almost all the aforementioned peaks appeared with slight changes either in the intensity of the signals or the positions of the peaks. The similar FT-IR pattern of both pure cranberry extract and Ag NPs strongly suggests the presence of identical phytomolecules in the samples. This confirms the dual function of the phytoconstituents of cranberries, both in the formation and stabilization of the resulting Ag NPs.
The possible mechanism of the formation of Ag NPs from the extract of cranberries could be as follows. The preparation of Ag NPs may involve electron transfer from phenolic compounds to Ag+ ions, which are abundantly present in the cranberry extract in the form of diverse polyphenols [41]. Studies have indicated the presence of quercetin in large amounts in a variety of cranberries; this is a plant flavonol from the flavonoid group of polyphenols [42]. Since polyphenols like quercetin and others are electron-rich compounds, they potentially offer free electrons, which facilitate the reduction of silver ions. These compounds not only function as reducing agents but also stabilize the surface of the resulting Ag NPs. For instance, after the reduction of silver ions, polyphenolic constituents such as quercetin and other flavonols actively oxidized to their respective oxidized intermediates, such as quercetin quinone, semiquinone radicals and other derivatives [43]. These unstable oxidized derivatives of polyphenols are prone to interact with nanoparticle surfaces, which leads to the stabilization of the resulting Ag NPs by capping them onto the surface [44]. This was indeed proven by the FT-IR and UV results, which indicated the presence of phytoconstituents on the surface of the resulting Ag NPs.
3.1. Biological Application
3.1.1. The Effect of Green Synthesized Ag NPs on Mycelial Growth
The silver nanoparticles synthesized from cranberries exhibited potent antifungal activity against all the tested pathogenic fungi in a significant manner (p ≥ 0.05). The mycelial growth inhibition was concentration-dependent; as the concentration increased, the inhibition also increased. As depicted in Table 1 and Figure 5, the maximum inhibition of fungal growth was at the highest test concentration of 64 µg/mL. Fusarium solani had the smallest mycelial colony growth (13 mm) at 64 µg/mL, and the cranberry Ag NPs had a strong inhibitory effect on F. solani mycelial growth, as the colony was quite shriveled. The NPs also inhibited F. oxysporum (15 mm), Cladosporium herbarum (19 mm) and Pestalotiopsis mangiferae (27 mm) effectively. Correspondingly, the highest percentage of mycelial growth inhibition was exhibited by F. solani (85%), F. oxysporum (83%), C. herbarum (78%) and P. mangiferae (70%) at 64 μg/mL (Figure 5 and Figure 6, Table 1). The fungicides (C + M-0.1%) also caused significant growth inhibition of all the fungal pathogens screened, as shown in Table 1. It was observed that the fungicide had a stronger inhibitory effect on C. herbarum, Alternaria alternata, and A. solani in comparison to Cb-NPs. The fungicide caused 92% mycelial growth inhibition of C. herbarum, followed by Alternaria alternata (77%), Helminthosporium solani (70%), and A. solani (65%), which were all greater than the Cb-NPs (Figure 6). However, the Cb-AgNPs were more potent than the fungicide in inhibiting both F. solani and F. oxyxporum. Studies have suggested that the fungicidal properties of Ag NPs originate from their efficient ability to interact with the fungal cell membranes, and their high cell membrane permeability [45]. The interaction of Ag NPs with the cell membranes potentially destroys gradients between cytoplasmic membranes and may also disturb the membrane conformity, which may induce cell death [46]. Ag NPs are also known to induce ROS generation by disturbing the redox balance, which is one of the major causes of cellular damage [47].

Table 1.
The diameter of the colony growth of fungal isolates treated with cranberry Ag NPs, cranberry extracts, AgNO3 and the fungicide.

Figure 5.
Antifungal activity of the synthesized Ag NPs against several pathogenic fungi: (A) mycelial growth in control plate (not treated); (B) treated with synthesized cranberry Ag NPs; (C) treated with fungicide (C + M-0.1%). 1–7: Fungal isolates.

Figure 6.
The effect of cranberry extract and synthesized silver nanoparticles (64 μg/mL) on the percentage mycelial growth inhibition of fungal test isolates. The values shown in the graph are an average of three experimental replicates (±SD). Significant differences in means (p ≤ 0.05) were determined by analysis of variance (ANOVA) and Turkey HSD.
All values shown in the table are means of three independent experimental replicates (±SD). Significant difference in means (p ≤ 0.05) was determined by analysis of variance (ANOVA) and Tukey’s HSD.
3.1.2. Effect of Green Synthesized Ag NPs on Spore Germination
The synthesized NPs had remarkable inhibitory activity on the spore germination of all the fungal pathogens, but in a variable manner. The synthesized nanoparticles at 64 μg/mL decreased the spore germination to 10% in F. solani, 16% in F. oxysporum and 29% in H. solani. The fungicide (positive control) decreased the spore germination to 8% in C. herbarum and 18% in F. oxysporum (Figure 7). However, the aqueous extract and silver nitrate, on the other hand, had no significant inhibitory effect on the spore germination of any of the fungal pathogens tested. The negative control, which consisted of distilled water, did not inhibit the spore germination (Figure 7). The hyphal fragments and spores are ubiquitous components of the atmosphere and aid the fungi in growth and proliferation. Fungal pathogens reproduce by producing spores, which are dispersed by air. Upon landing on a suitable substrate, they germinate, allowing the hyphae to spread and proliferate, invading tissues and causing various diseases in humans, animals and plants. Therefore, the primary step in controlling infections is arresting spore germination. The robust inhibitory activity exhibited by cranberry NPs on spore germination in this study indicates their potential to be employed as excellent fungicides as an alternative to synthetic chemical fungicides.

Figure 7.
Percentage spore germination of fungal test pathogens treated with synthesized cranberry silver nanoparticles at 64 µg/mL−1.
3.1.3. DPPH Radical Scavenging Assay
Figure 8 illustrates the DPPH radical scavenging activity of cranberry Ag NPs, wherein ascorbic acid was used as a standard antioxidant. It was observed that the DPPH radical scavenging activity of the tested samples was dose-dependent and increased with the increase in concentration (25 μg/mL−1–200 μg/mL−1). The highest antioxidant activity of cranberry NPs was recorded at 200 μg/mL−1 concentration, which corresponded to 88%. However, the scavenging activity of the standard ascorbic acid was comparatively higher (93%) than that of the synthesized Ag NPs. The IC50 value recorded for cranberry Ag NPs in this study was 10.36 ± 0.33 μg/mL, comparable to the IC50 value of the standard ascorbic acid, which was 5.97 ± 0.05 μg/mL.

Figure 8.
DPPH free radical scavenging ability of the synthesized cranberry Ag NPs.
4. Discussion
The present study demonstrates the significant antifungal activity of Ag NPs derived from cranberry extract against some fungal pathogens. To our knowledge, this is the first investigation that demonstrates the inhibitory effect of cranberry nanoparticles against a wide array of fungal pathogens. The results of this study revealed that cranberry nanoparticles were highly potent in inhibiting the fungal pathogens, which was closely comparable to the fungicide used, especially with some fungal isolates. Additionally, the NPs significantly reduced spore germination.
Cranberries are known for their health-benefiting properties, as they are a rich source of several diverse phytochemical constituents and nutritional components [21]. The berries possess anthocyanins, flavonols, phenolic acids, proanthocyanidins (PCAs) and triterpenoids [48,49,50]. The findings of the present study are consistent with an earlier report, wherein cranberry juice demonstrated substantial inhibition of dermatophytes [51]. The dermatophytes Microsporum canis, M. audouini, M. gypseum, Trichophyton schoenleinii, T. rubrum, T. mentagrophyte and Epidermophyton flococssum were significantly inhibited, whereas T. tonsurans showed minimal growth inhibition, indicating its resistance to cranberry juice. Cranberry concentrates (V. macrocarpon Aiton and Vaccinium oxycoccos L.) significantly inhibited xerophillic fungi belonging to the genera Eurotium and Penicillium and non-xerophillic isolates, namely Penicillium brevicompactum, Zygosaccharomyces bailii, Saccharomyces cerevisiae and Absidia glauca [52].
Cranberry juice fractions (methanol, enriched in PACs) and crude extracts exhibited potential anti-adhesion properties against the oral fungi C. glabrata and C. albicans. The findings demonstrate that cranberry juice and the methanolic fraction prevented the formation of biofilm, especially in C. glabrata. However, the extracts and fractions of methanol did not exhibit antifungal activity against the Candidia albicans and C. glabrata species with an MIC assay. Corresponding results showing the anti-adhesion properties of cranberry juice were reported with Candida spp. [53,54].
Cranberries’ antimicrobial activity is primarily attributed to their diverse bioactive compounds, such as phenols, flavonoids, tannins and proanthocyanidins, which contribute immensely to antimicrobial activity [55]. The antimicrobial effects of fruits are associated with significant amounts of phenolic compounds, and cranberry is no exception, as it possesses high amounts of low-molecular-weight phenolic acids, proanthocyanidins, flavonols, condensed tannins and anthocyanins [56,57]. It is documented that one of the key elements of cranberries that protect against pathogenic microorganisms is the proanthocyanidin, a polymeric tannin [58,59].
The significant inhibition of fungal isolates exhibited by the AgNPs in comparison to the extracts in this study could be due to the small size of the nanoparticles, which enables easy adherence and penetration [60]. A large number of small sized NPs can occupy a large surface area on the cell wall and cell membrane, making the NPs more biologically effective and biocompatible [61]. The vital bioactive compounds of the extract aid in capping and reduction, providing stability to the synthesized NPs [62]. The antifungal activity of cranberry silver nanoparticles in this study could be attributed to the synergistic activity of several phytochemical constituents, especially the polyphenols. Several polyphenols, such as anthocyanins, flavonoids, flavones and tannins, have been identified in cranberries in previous studies [50,63,64,65]. Earlier studies have demonstrated the antifungal properties of polyphenols against Botrytis cinerea, F. oxysporum and Candida albicans [66,67]. A study demonstrated that polyphenols and saponins induced the endogenous production of ROS, which led to lipid peroxidation and resulted in the leakage of cellular contents due to cell membrane damage in Rhizopus stolonilfer [68]. The antifungal properties of some phenolic compounds have been said to induce apoptosis, enzyme inactivation, and a reduction in the synthesis of ergosterol in Candida species [69,70,71]. Flavonoids are known to be vital in inhibiting the cytochrome P450 pathway and steroid hydroxylase, which directly impact the growth of microorganisms [72].
The mechanisms of the antifungal activity of Ag NPs remain unclear, and the exact mode of action is still debatable. The competence of Ag NPs to integrate with fungal cell membranes could be one reason for this [73]. It has been stated that the antifungal activity could be either from the silver ions or Ag NPs [74]. The affinity of silver ions (Ag0) towards some groups of cell membranes, such as sulfhydryl, eases the release from Ag NPs and allows adherence to the cell membrane, which in turn disturbs the cell’s stability, easing penetration and resulting in rapid entry of Ag0 into the cell cytoplasm [75]. Another view is that the NPs have the ability to adhere to the cell and damage the chitin and ergosterol of the fungal cell wall and cell membrane. This causes osmotic imbalance, which increases the permeability of NPS, resulting in an uncontrolled inflow of NPs into the cell cytoplasm, disrupting vital molecules and organelles and generating ROS and free radicals, which induces oxidative stress and results in cell instability and death [76,77]. The biosynthesized Cb-AgNPs exhibited significant inhibitory activity against fungal isolates, which could be a synergistic effect of the size and shape of the NPs and the diverse array of bioactive compounds that served as coating agents.
Similar to the present study, a previous study showed dose-dependent radical scavenging activity, and an IC50 of 4.8 mg/mL was recorded for cranberry extracts, while the IC50 value for ascorbic acid in powdered cranberries was 0.5 mg/mL [78]. In another study, frozen cranberry extracts, purified compounds, fractions of cranberry extracts, and standards (myricetin and quercetin) were tested for their radical scavenging activity with the DPPH assay, and the IC50 values ranged between 3.5 and 15 µg/mL [79]. Thus, based on the results of the DPPH assay in this study, it can be concluded that cranberry silver NPs have significant free radical scavenging activity, which could be attributed to the diverse phytochemical constituents. Cranberries are a rich source of several polyphenols (phenolic acids, flavonoids, tannins and anthocyanins) and triterpenes and are associated with antioxidant activity [19,22]. Polyphenols are excellent antioxidants, as they are highly competent in breaking the free radical chain, inhibiting enzyme activity, metal chelation and singlet oxygen quenching [22,80,81]. Peaks related to polyphenols, flavonoids, amines, proteins and aromatic esters were quite evident in the IR spectra of cranberry extracts and Ag NPs in this study. Previous studies have demonstrated the radical scavenging activity of flavanol glycosides, phenols and anthocyandins isolated from cranberry extracts [78,79].
5. Conclusions
This study demonstrated that the cranberry (Vaccinium oxycoccos) extract can be effective for the eco-friendly and efficient reduction of AgNO3 into well-defined, spherical Ag NPs of an average diameter of 5–25 nm. The crystallinity of the materials was proven by XRD analysis. FT-IR results confirmed that the as-prepared Ag NPs were stabilized by the presence of secondary metabolites of cranberry extract, which also acted as a capping ligand. However, a detail investigation is still required to explore the active phytoconstituents that is actually responsible for the bio-reduction process. Furthermore, the biological potential of the as-obtained Ag NPs was revealed in the present study by evaluating the antifungal and antioxidant potential. The synthesized silver nanoparticles reduced the mycelial growth and spore germination rate substantially. The potent biological properties shown by cranberry Ag NPs can be ascribed mainly to the smaller and highly stable nature of the nanoparticles and the polyphenols present in the cranberries. Thus, the biosynthesized NPs obtained in this study possess excellent scope in a variety of biological applications.
Author Contributions
Conceptualization, H.R.; methodology, H.R.; software, H.A.A.; validation, H.R. and M.K.; formal analysis, H.A.A., S.F.A., M.R.S., M.E.A., M.R.H. and M.R.H.S.; investigation, H.R., H.A.A. and M.R.S.; resources, H.R.; data curation, H.R., M.R.S. and M.K.; writing—original draft preparation, H.R. and M.K.; writing—review and editing, H.R., H.A.A., M.R.S. and M.K.; visualization, H.R.; supervision, H.R. and M.K.; project administration, H.R. All authors have read and agreed to the published version of the manuscript.
Funding
Researchers Supporting Project number (RSPD2023R665), King Saud University, Riyadh, Saudi Arabia.
Data Availability Statement
Data are contained within the article.
Acknowledgments
The authors acknowledge the funding from Researchers Supporting Project number (RSPD2023R665), King Saud University, Riyadh, Saudi Arabia.
Conflicts of Interest
The authors declare no conflict of interest.
References
- Dikshit, P.K.; Kumar, J.; Das, A.K.; Sadhu, S.; Sharma, S.; Singh, S.; Gupta, P.K.; Kim, B.S. Green synthesis of metallic nanoparticles: Applications and limitations. Catalysts 2021, 11, 902. [Google Scholar] [CrossRef]
- Hemanth, N.; Mohili, R.D.; Patel, M.; Jadhav, A.H.; Lee, K.; Chaudhari, N.K. Metallic nanosponges for energy storage and conversion applications. J. Mater. Chem. A 2022, 10, 14221–14246. [Google Scholar] [CrossRef]
- Tan, H.W.; An, J.; Chua, C.K.; Tran, T. Metallic nanoparticle inks for 3D printing of electronics. Adv. Electron. Mater. 2019, 5, 1800831. [Google Scholar] [CrossRef]
- Gayda, G.Z.; Demkiv, O.M.; Stasyuk, N.Y.; Serkiz, R.Y.; Lootsik, M.D.; Errachid, A.; Gonchar, M.V.; Nisnevitch, M. Metallic nanoparticles obtained via “green” synthesis as a platform for biosensor construction. Appl. Sci. 2019, 9, 720. [Google Scholar] [CrossRef]
- Shenashen, M.A.; El-Safty, S.A.; Elshehy, E.A. Synthesis, morphological control, and properties of silver nanoparticles in potential applications. Part. Part. Syst. Charact. 2014, 31, 293–316. [Google Scholar] [CrossRef]
- Sampath, G.; Govarthanan, M.; Rameshkumar, N.; Vo, D.-V.N.; Krishnan, M.; Sivasankar, P.; Kayalvizhi, N. Eco-friendly biosynthesis metallic silver nanoparticles using Aegle marmelos (Indian bael) and its clinical and environmental applications. Appl. Nanosci. 2021, 13, 663–674. [Google Scholar] [CrossRef]
- Bruna, T.; Maldonado-Bravo, F.; Jara, P.; Caro, N. Silver nanoparticles and their antibacterial applications. Int. J. Mol. Sci. 2021, 22, 7202. [Google Scholar] [CrossRef]
- Ahmad, A.; Wei, Y.; Syed, F.; Tahir, K.; Rehman, A.U.; Khan, A.; Ullah, S.; Yuan, Q. The effects of bacteria-nanoparticles interface on the antibacterial activity of green synthesized silver nanoparticles. Microb. Pathog. 2017, 102, 133–142. [Google Scholar] [CrossRef]
- Chakraborty, B.; Pal, R.; Ali, M.; Singh, L.M.; Shahidur Rahman, D.; Kumar Ghosh, S.; Sengupta, M. Immunomodulatory properties of silver nanoparticles contribute to anticancer strategy for murine fibrosarcoma. Cell. Mol. Immunol. 2016, 13, 191–205. [Google Scholar] [CrossRef]
- Benyettou, F.; Rezgui, R.; Ravaux, F.; Jaber, T.; Blumer, K.; Jouiad, M.; Motte, L.; Olsen, J.-C.; Platas-Iglesias, C.; Magzoub, M. Synthesis of silver nanoparticles for the dual delivery of doxorubicin and alendronate to cancer cells. J. Mater. Chem. B 2015, 3, 7237–7245. [Google Scholar] [CrossRef]
- Rana, K.; Pandey, S.K.; Chauhan, S.; Preet, S. Anticancer therapeutic potential of 5-fluorouracil and nisin co-loaded chitosan coated silver nanoparticles against murine skin cancer. Int. J. Pharm. 2022, 620, 121744. [Google Scholar] [CrossRef]
- Wahab, M.A.; Li, L.; Li, H.; Abdala, A. Silver nanoparticle-based nanocomposites for combating infectious pathogens: Recent advances and future prospects. Nanomaterials 2021, 11, 581. [Google Scholar] [CrossRef]
- Rajput, N. Methods of preparation of nanoparticles—A review. Int. J. Adv. Eng. Technol. 2015, 7, 1806. [Google Scholar]
- Khan, M.; Shaik, M.R.; Adil, S.F.; Khan, S.T.; Al-Warthan, A.; Siddiqui, M.R.H.; Tahir, M.N.; Tremel, W. Plant extracts as green reductants for the synthesis of silver nanoparticles: Lessons from chemical synthesis. Dalton Trans. 2018, 47, 11988–12010. [Google Scholar] [CrossRef]
- Adil, S.F.; Assal, M.E.; Khan, M.; Al-Warthan, A.; Siddiqui, M.R.H.; Liz-Marzán, L.M. Biogenic synthesis of metallic nanoparticles and prospects toward green chemistry. Dalton Trans. 2015, 44, 9709–9717. [Google Scholar] [CrossRef]
- Jain, A.S.; Pawar, P.S.; Sarkar, A.; Junnuthula, V.; Dyawanapelly, S. Bionanofactories for green synthesis of silver nanoparticles: Toward antimicrobial applications. Int. J. Mol. Sci. 2021, 22, 11993. [Google Scholar] [CrossRef]
- Ocsoy, I.; Tasdemir, D.; Mazicioglu, S.; Celik, C.; Katı, A.; Ulgen, F. Biomolecules incorporated metallic nanoparticles synthesis and their biomedical applications. Mater. Lett. 2018, 212, 45–50. [Google Scholar] [CrossRef]
- Khan, M.; Khan, M.; Adil, S.F.; Tahir, M.N.; Tremel, W.; Alkhathlan, H.Z.; Al-Warthan, A.; Siddiqui, M.R.H. Green synthesis of silver nanoparticles mediated by Pulicaria glutinosa extract. Int. J. Nanomed. 2013, 8, 1507–1516. [Google Scholar]
- Skrovankova, S.; Sumczynski, D.; Mlcek, J.; Jurikova, T.; Sochor, J. Bioactive compounds and antioxidant activity in different types of berries. Int. J. Mol. Sci. 2015, 16, 24673–24706. [Google Scholar] [CrossRef]
- Bilawal, A.; Ishfaq, M.; Gantumur, M.-A.; Qayum, A.; Shi, R.; Fazilani, S.A.; Anwar, A.; Jiang, Z.; Hou, J. A review of the bioactive ingredients of berries and their applications in curing diseases. Food Biosci. 2021, 44, 101407. [Google Scholar] [CrossRef]
- Nemzer, B.V.; Al-Taher, F.; Yashin, A.; Revelsky, I.; Yashin, Y. Cranberry: Chemical Composition, Antioxidant Activity and Impact on Human Health: Overview. Molecules 2022, 27, 1503. [Google Scholar] [CrossRef] [PubMed]
- Jurikova, T.; Skrovankova, S.; Mlcek, J.; Balla, S.; Snopek, L. Bioactive compounds, antioxidant activity, and biological effects of European cranberry (Vaccinium oxycoccos). Molecules 2018, 24, 24. [Google Scholar] [CrossRef] [PubMed]
- Česonienė, L.; Jasutienė, I.; Šarkinas, A. Phenolics and anthocyanins in berries of European cranberry and their antimicrobial activity. Medicina 2009, 45, 992. [Google Scholar] [CrossRef]
- Česonienė, L.; Daubaras, R.; Jasutienė, I.; Miliauskienė, I.; Zych, M. Investigations of anthocyanins, organic acids, and sugars show great variability in nutritional value of European cranberry (Vaccinium oxycoccos) fruit. J. Appl. Bot. Food Qual. 2015, 88, 295–299. [Google Scholar]
- Xia, J.-Y.; Yang, C.; Xu, D.-F.; Xia, H.; Yang, L.-G.; Sun, G.-J. Consumption of cranberry as adjuvant therapy for urinary tract infections in susceptible populations: A systematic review and meta-analysis with trial sequential analysis. PLoS ONE 2021, 16, e0256992. [Google Scholar] [CrossRef] [PubMed]
- Rizwana, H.; Bokahri, N.A.; Alkhattaf, S.F.; Albasher, G.; Aldehaish, A.H. Antifungal, antibacterial, and cytotoxic activities of silver nanoparticles synthesized from aqueous extracts of mace-arils of Myristica fragrans. Molecules 2021, 26, 7709. [Google Scholar] [CrossRef] [PubMed]
- Kim, S.W.; Jung, J.H.; Lamsal, K.; Kim, Y.S.; Min, J.S.; Lee, Y.S. Antifungal effects of silver nanoparticles (AgNPs) against various plant pathogenic fungi. Mycobiology 2012, 40, 53–58. [Google Scholar] [CrossRef]
- Ibrahim, E.; Luo, J.; Ahmed, T.; Wu, W.; Yan, C.; Li, B. Biosynthesis of silver nanoparticles using onion endophytic bacterium and its antifungal activity against rice pathogen Magnaporthe oryzae. J. Fungi 2020, 6, 294. [Google Scholar] [CrossRef]
- Rizwana, H. Postharvest control of anthracnose lesions and its causative agent, Colletotrichum musae by some oils. Cell. Mol. Biol. 2018, 64, 52–58. [Google Scholar] [CrossRef]
- Tawfik, A.; Younis, S.; Koriem, A.; Elian, M. ANTIFUNGAL ACTIVITY OF SOME ESSENTIAL OILS AGAINST POST-HARVEST FRUIT ROT OF SWEET PEPPER. J. Product. Dev. 2021, 26, 447–462. [Google Scholar] [CrossRef]
- Venkatesan, J.; Kim, S.-K.; Shim, M.S. Antimicrobial, antioxidant, and anticancer activities of biosynthesized silver nanoparticles using marine algae Ecklonia cava. Nanomaterials 2016, 6, 235. [Google Scholar] [CrossRef]
- Patel Rajesh, M.; Patel Natvar, J. In vitro antioxidant activity of coumarin compounds by DPPH, Super oxide and nitric oxide free radical scavenging methods. J. Adv. Pharm. Educ. Res. 2011, 1, 52–68. [Google Scholar]
- Shameli, K.; Ahmad, M.B.; Zamanian, A.; Sangpour, P.; Shabanzadeh, P.; Abdollahi, Y.; Zargar, M. Green biosynthesis of silver nanoparticles using Curcuma longa tuber powder. Int. J. Nanomed. 2012, 7, 5603. [Google Scholar] [CrossRef]
- dos Santos Grasel, F.; Ferrão, M.F.; Wolf, C.R. Ultraviolet spectroscopy and chemometrics for the identification of vegetable tannins. Ind. Crops Prod. 2016, 91, 279–285. [Google Scholar] [CrossRef]
- Gierschner, J.; Duroux, J.-L.; Trouillas, P. UV/Visible spectra of natural polyphenols: A time-dependent density functional theory study. Food Chem. 2012, 131, 79–89. [Google Scholar]
- Kasthuri, J.; Veerapandian, S.; Rajendiran, N. Biological synthesis of silver and gold nanoparticles using apiin as reducing agent. Colloids Surf. B Biointerfaces 2009, 68, 55–60. [Google Scholar] [CrossRef]
- Elgorban, A.M.; El-Samawaty, A.E.-R.M.; Abd-Elkader, O.H.; Yassin, M.A.; Sayed, S.R.; Khan, M.; Adil, S.F. Bioengineered silver nanoparticles using Curvularia pallescens and its fungicidal activity against Cladosporium fulvum. Saudi J. Biol. Sci. 2017, 24, 1522–1528. [Google Scholar] [CrossRef]
- Singhal, G.; Bhavesh, R.; Kasariya, K.; Sharma, A.R.; Singh, R.P. Biosynthesis of silver nanoparticles using Ocimum sanctum (Tulsi) leaf extract and screening its antimicrobial activity. J. Nanopart. Res. 2011, 13, 2981–2988. [Google Scholar] [CrossRef]
- Zepon, K.M.; Martins, M.M.; Marques, M.S.; Heckler, J.M.; Morisso, F.D.P.; Moreira, M.G.; Ziulkoski, A.L.; Kanis, L.A. Smart wound dressing based on κ-carrageenan/locust bean gum/cranberry extract for monitoring bacterial infections. Carbohydr. Polym. 2019, 206, 362–370. [Google Scholar] [CrossRef]
- Wongsa, P.; Phatikulrungsun, P.; Prathumthong, S. FT-IR characteristics, phenolic profiles and inhibitory potential against digestive enzymes of 25 herbal infusions. Sci. Rep. 2022, 12, 6631. [Google Scholar] [CrossRef]
- Neto, C.C. Cranberry and its phytochemicals: A review of in vitro anticancer studies. J. Nutr. 2007, 137, 186S–193S. [Google Scholar] [CrossRef] [PubMed]
- Seeram, N.P.; Adams, L.S.; Zhang, Y.; Lee, R.; Sand, D.; Scheuller, H.S.; Heber, D. Blackberry, black raspberry, blueberry, cranberry, red raspberry, and strawberry extracts inhibit growth and stimulate apoptosis of human cancer cells in vitro. J. Agric. Food Chem. 2006, 54, 9329–9339. [Google Scholar] [CrossRef] [PubMed]
- Zhu, M.; Han, S.; Fink, A.L. Oxidized quercetin inhibits α-synuclein fibrillization. Biochim. Et Biophys. Acta (BBA)-Gen. Subj. 2013, 1830, 2872–2881. [Google Scholar] [CrossRef] [PubMed]
- Bhutto, A.A.; Kalay, Ş.; Sherazi, S.; Culha, M. Quantitative structure-activity relationship between antioxidant capacity of phenolic compounds and the plasmonic properties of silver nanoparticles. Talanta 2018, 189, 174–181. [Google Scholar] [CrossRef] [PubMed]
- Zhou, L.; Zhao, X.; Li, M.; Lu, Y.; Ai, C.; Jiang, C.; Liu, Y.; Pan, Z.; Shi, J. Antifungal activity of silver nanoparticles synthesized by iturin against Candida albicans in vitro and in vivo. Appl. Microbiol. Biotechnol. 2021, 105, 3759–3770. [Google Scholar] [CrossRef]
- Nasrollahi, A.; Pourshamsian, K.; Mansourkiaee, P. Antifungal activity of silver nanoparticles on some of fungi. Int. J. Nano Dimens. 2011, 1, 233–239. [Google Scholar]
- Tian, X.; Jiang, X.; Welch, C.; Croley, T.R.; Wong, T.-Y.; Chen, C.; Fan, S.; Chong, Y.; Li, R.; Ge, C. Bactericidal effects of silver nanoparticles on lactobacilli and the underlying mechanism. ACS Appl. Mater. Interfaces 2018, 10, 8443–8450. [Google Scholar] [CrossRef]
- Česonienė, L.; Daubaras, R. Phytochemical composition of the large cranberry (Vaccinium macrocarpon) and the small cranberry (Vaccinium oxycoccos). In Nutritional Composition of Fruit Cultivars; Simmonds, M.S.J., Preedy, V.R., Eds.; Elsevier: Amsterdam, The Netherlands, 2016; pp. 173–194. [Google Scholar]
- Tikuma, B.; Liepniece, M.; Sterne, D.; Abolins, M.; Seglina, D.; Krasnova, I. Preliminary results of biochemical composition of two cranberry species grown in Latvia. In Proceedings of the X International Symposium on Vaccinium and Other Superfruits 1017, Maastricht, The Netherlands, 17–22 June 2012; pp. 209–214. [Google Scholar]
- Wu, X.; Xue, L.; Tata, A.; Song, M.; Neto, C.C.; Xiao, H. Bioactive components of polyphenol-rich and non-polyphenol-rich cranberry fruit extracts and their chemopreventive effects on colitis-associated colon cancer. J. Agric. Food Chem. 2020, 68, 6845–6853. [Google Scholar] [CrossRef]
- Swartz, J.H.; Medrek, T.F. Antifungal properties of cranberry juice. Appl. Microbiol. 1968, 16, 1524–1527. [Google Scholar] [CrossRef]
- Ermis, E.; Hertel, C.; Schneider, C.; Carle, R.; Stintzing, F.; Schmidt, H. Characterization of in vitro antifungal activities of small and American cranberry (Vaccinium oxycoccos L. and V. macrocarpon Aiton) and lingonberry (Vaccinium vitis-idaea L.) concentrates in sugar reduced fruit spreads. Int. J. Food Microbiol. 2015, 204, 111–117. [Google Scholar] [CrossRef]
- Feldman, M.; Tanabe, S.; Howell, A.; Grenier, D. Cranberry proanthocyanidins inhibit the adherence properties of Candida albicans and cytokine secretion by oral epithelial cells. BMC Complement. Altern. Med. 2012, 12, 6. [Google Scholar] [CrossRef]
- Rane, H.S.; Bernardo, S.M.; Howell, A.B.; Lee, S.A. Cranberry-derived proanthocyanidins prevent formation of Candida albicans biofilms in artificial urine through biofilm-and adherence-specific mechanisms. J. Antimicrob. Chemother. 2014, 69, 428–436. [Google Scholar] [CrossRef]
- Wu, V.C.-H.; Qiu, X.; Bushway, A.; Harper, L. Antibacterial effects of American cranberry (Vaccinium macrocarpon) concentrate on foodborne pathogens. LWT-Food Sci. Technol. 2008, 41, 1834–1841. [Google Scholar] [CrossRef]
- Häkkinen, S.; Heinonen, M.; Kärenlampi, S.; Mykkänen, H.; Ruuskanen, J.; Törrönen, R. Screening of selected flavonoids and phenolic acids in 19 berries. Food Res. Int. 1999, 32, 345–353. [Google Scholar] [CrossRef]
- Leitão, D.P.; Polizello, A.C.M.; Ito, I.Y.; Spadaro, A.C.C. Antibacterial screening of anthocyanic and proanthocyanic fractions from cranberry juice. J. Med. Food 2005, 8, 36–40. [Google Scholar] [CrossRef]
- Foo, L.Y.; Lu, Y.; Howell, A.B.; Vorsa, N. The structure of cranberry proanthocyanidins which inhibit adherence of uropathogenic P-fimbriated Escherichia coli in vitro. Phytochemistry 2000, 54, 173–181. [Google Scholar] [CrossRef]
- Heinonen, M. Antioxidant activity and antimicrobial effect of berry phenolics—A Finnish perspective. Mol. Nutr. Food Res. 2007, 51, 684–691. [Google Scholar] [CrossRef]
- Augustine, R.; Hasan, A. Emerging applications of biocompatible phytosynthesized metal/metal oxide nanoparticles in healthcare. J. Drug Deliv. Sci. Technol. 2020, 56, 101516. [Google Scholar] [CrossRef]
- Vanlalveni, C.; Lallianrawna, S.; Biswas, A.; Selvaraj, M.; Changmai, B.; Rokhum, S.L. Correction: Green synthesis of silver nanoparticles using plant extracts and their antimicrobial activities: A review of recent literature. RSC Adv. 2022, 12, 16093. [Google Scholar] [CrossRef]
- Chandra, H.; Kumari, P.; Bontempi, E.; Yadav, S. Medicinal plants: Treasure trove for green synthesis of metallic nanoparticles and their biomedical applications. Biocatal. Agric. Biotechnol. 2020, 24, 101518. [Google Scholar] [CrossRef]
- Prior, R.L.; Lazarus, S.A.; Cao, G.; Muccitelli, H.; Hammerstone, J.F. Identification of procyanidins and anthocyanins in blueberries and cranberries (Vaccinium spp.) using high-performance liquid chromatography/mass spectrometry. J. Agric. Food Chem. 2001, 49, 1270–1276. [Google Scholar] [CrossRef] [PubMed]
- Diarra, M.S.; Block, G.; Rempel, H.; Oomah, B.D.; Harrison, J.; McCallum, J.; Boulanger, S.; Brouillette, É.; Gattuso, M.; Malouin, F. In vitro and in vivo antibacterial activities of cranberry press cake extracts alone or in combination with β-lactams against Staphylococcus aureus. BMC Complement. Altern. Med. 2013, 13, 90. [Google Scholar] [CrossRef] [PubMed]
- Karaaslan, N.M.; Yaman, M. Determination of anthocyanins in cherry and cranberry by high-performance liquid chromatography-electrospray ionization-mass spectrometry. Eur. Food Res. Technol. 2016, 242, 127–135. [Google Scholar] [CrossRef]
- Elansary, H.O.; Salem, M.Z.; Ashmawy, N.A.; Yessoufou, K.; El-Settawy, A.A. In vitro antibacterial, antifungal and antioxidant activities of Eucalyptus spp. leaf extracts related to phenolic composition. Nat. Prod. Res. 2017, 31, 2927–2930. [Google Scholar] [CrossRef]
- Elansary, H.O.; Szopa, A.; Kubica, P.; Ekiert, H.; Ali, H.M.; Elshikh, M.S.; Abdel-Salam, E.M.; El-Esawi, M.; El-Ansary, D.O. Bioactivities of traditional medicinal plants in Alexandria. Evid. Based Complement. Altern. Med. 2018, 2018, 1463579. [Google Scholar] [CrossRef]
- Jiang, X.; Feng, K.; Yang, X. In vitro antifungal activity and mechanism of action of tea polyphenols and tea saponin against Rhizopus stolonifer. Microb. Physiol. 2015, 25, 269–276. [Google Scholar] [CrossRef]
- Zore, G.B.; Thakre, A.D.; Jadhav, S.; Karuppayil, S.M. Terpenoids inhibit Candida albicans growth by affecting membrane integrity and arrest of cell cycle. Phytomedicine 2011, 18, 1181–1190. [Google Scholar] [CrossRef]
- Ahmad, A.; Khan, A.; Manzoor, N.; Khan, L.A. Evolution of ergosterol biosynthesis inhibitors as fungicidal against Candida. Microb. Pathog. 2010, 48, 35–41. [Google Scholar] [CrossRef]
- Evensen, N.A.; Braun, P.C. The effects of tea polyphenols on Candida albicans: Inhibition of biofilm formation and proteasome inactivation. Can. J. Microbiol. 2009, 55, 1033–1039. [Google Scholar] [CrossRef]
- Arif, T.; Bhosale, J.; Kumar, N.; Mandal, T.; Bendre, R.; Lavekar, G.; Dabur, R. Natural products-antifungal agents derived from plants. J. Asian Nat. Prod. Res. 2009, 11, 621–638. [Google Scholar] [CrossRef]
- Mikhailova, E.O. Silver nanoparticles: Mechanism of action and probable bio-application. J. Funct. Biomater. 2020, 11, 84. [Google Scholar] [CrossRef]
- Cheng, L.; Li, R.; Liu, G.; Zhang, Y.; Tang, X.; Wang, J.; Liu, H.; Qin, Y. Potential antibacterial mechanism of silver nanoparticles and the optimization of orthopedic implants by advanced modification technologies. Int. J. Nanomed. 2018, 13, 3311. [Google Scholar]
- Klueh, U.; Wagner, V.; Kelly, S.; Johnson, A.; Bryers, J. Efficacy of silver-coated fabric to prevent bacterial colonization and subsequent device-based biofilm formation. J. Biomed. Mater. Res. 2000, 53, 621–631. [Google Scholar] [CrossRef]
- Kumari, M.; Giri, V.P.; Pandey, S.; Kumar, M.; Katiyar, R.; Nautiyal, C.S.; Mishra, A. An insight into the mechanism of antifungal activity of biogenic nanoparticles than their chemical counterparts. Pestic. Biochem. Physiol. 2019, 157, 45–52. [Google Scholar] [CrossRef]
- Bowman, S.M.; Free, S.J. The structure and synthesis of the fungal cell wall. Bioessays 2006, 28, 799–808. [Google Scholar] [CrossRef]
- Severo, C.; Anjos, I.; Souza, V.G.; Canejo, J.P.; Bronze, M.; Fernando, A.L.; Coelhoso, I.; Bettencourt, A.F.; Ribeiro, I.A. Development of cranberry extract films for the enhancement of food packaging antimicrobial properties. Food Packag. Shelf Life 2021, 28, 100646. [Google Scholar] [CrossRef]
- Yan, X.; Murphy, B.T.; Hammond, G.B.; Vinson, J.A.; Neto, C.C. Antioxidant activities and antitumor screening of extracts from cranberry fruit (Vaccinium macrocarpon). J. Agric. Food Chem. 2002, 50, 5844–5849. [Google Scholar] [CrossRef]
- Brown, P.N.; Turi, C.E.; Shipley, P.R.; Murch, S.J. Comparisons of large (Vaccinium macrocarpon Ait.) and small (Vaccinium oxycoccos L.; Vaccinium vitis-idaea L.) cranberry in British Columbia by phytochemical determination, antioxidant potential, and metabolomic profiling with chemometric analysis. Planta Med. 2012, 78, 630–640. [Google Scholar] [CrossRef]
- Atasoy, N.; Yücel, U.M. Antioxidants from Plant Sources and Free Radicals. In Reactive Oxygen Species; Ahmad, R., Ed.; IntechOpen: London, UK, 2021. [Google Scholar]
Disclaimer/Publisher’s Note: The statements, opinions and data contained in all publications are solely those of the individual author(s) and contributor(s) and not of MDPI and/or the editor(s). MDPI and/or the editor(s) disclaim responsibility for any injury to people or property resulting from any ideas, methods, instructions or products referred to in the content. |
© 2023 by the authors. Licensee MDPI, Basel, Switzerland. This article is an open access article distributed under the terms and conditions of the Creative Commons Attribution (CC BY) license (https://creativecommons.org/licenses/by/4.0/).